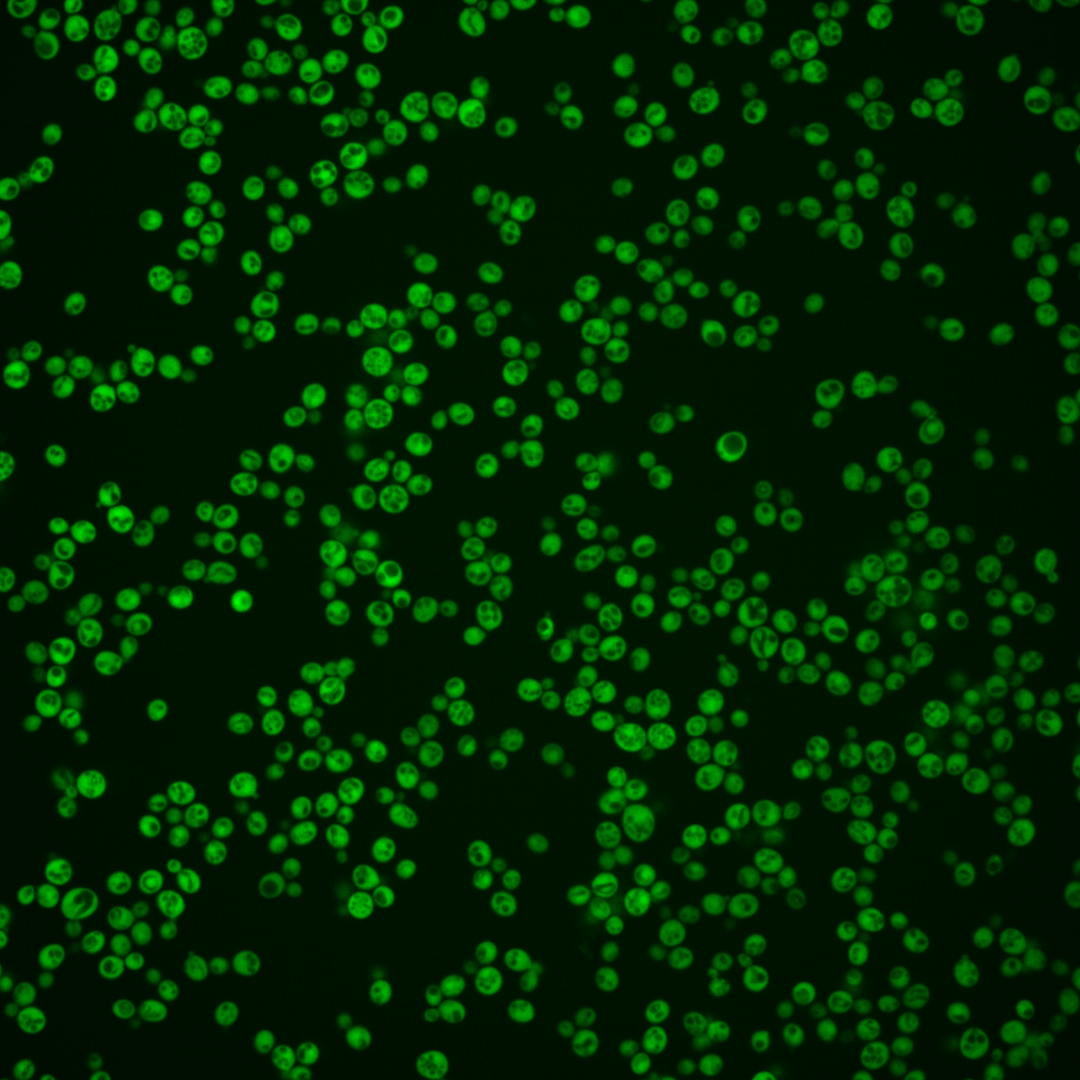
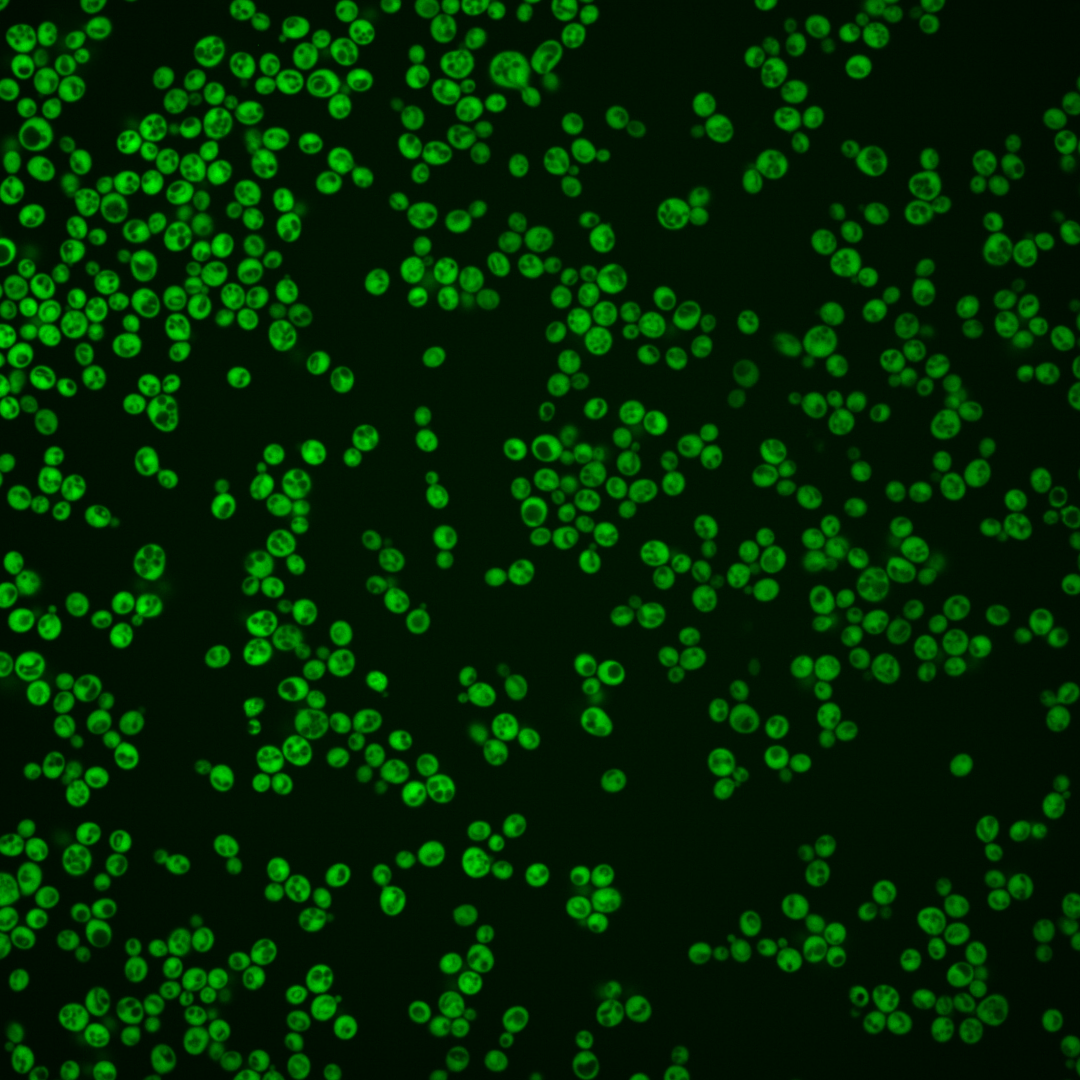
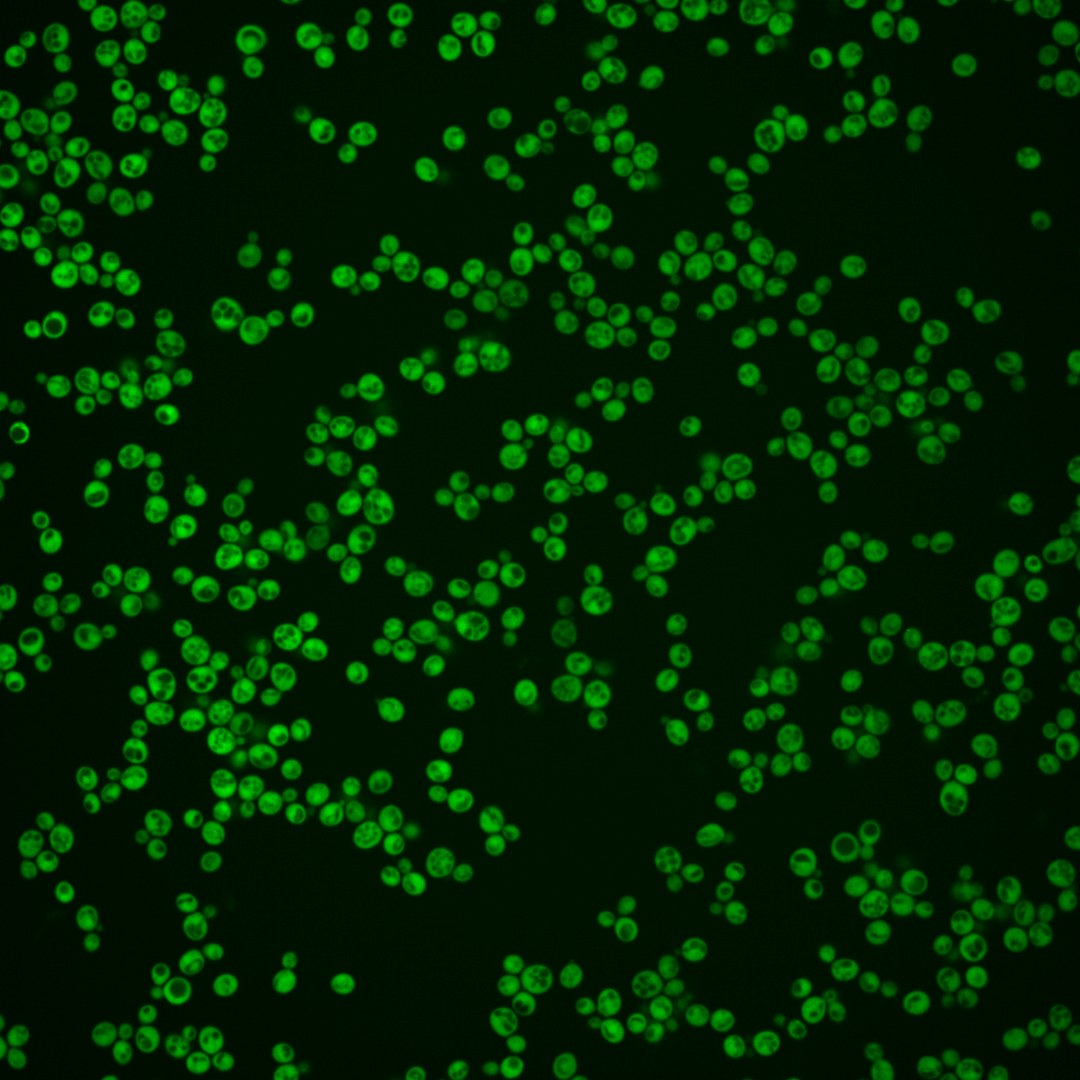
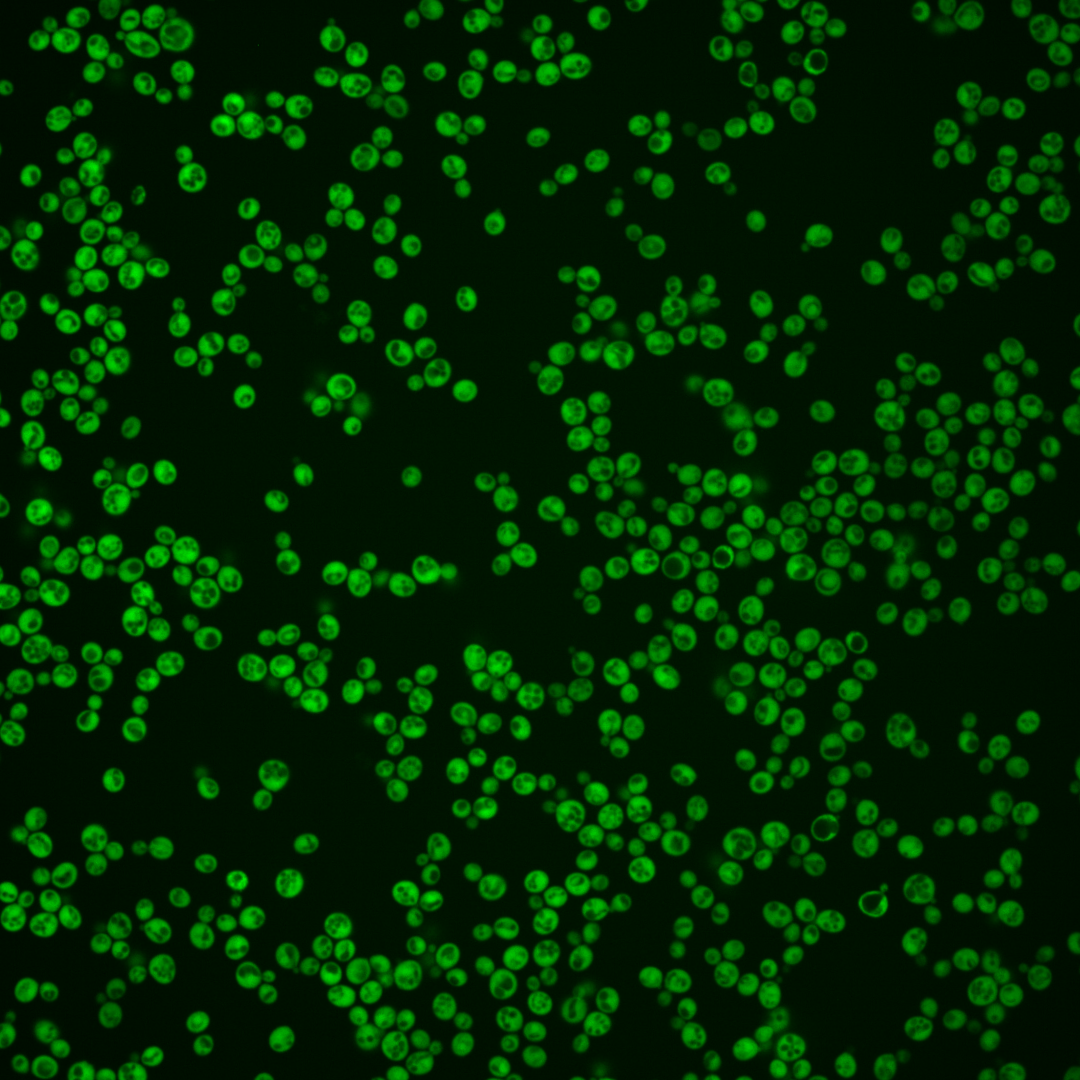
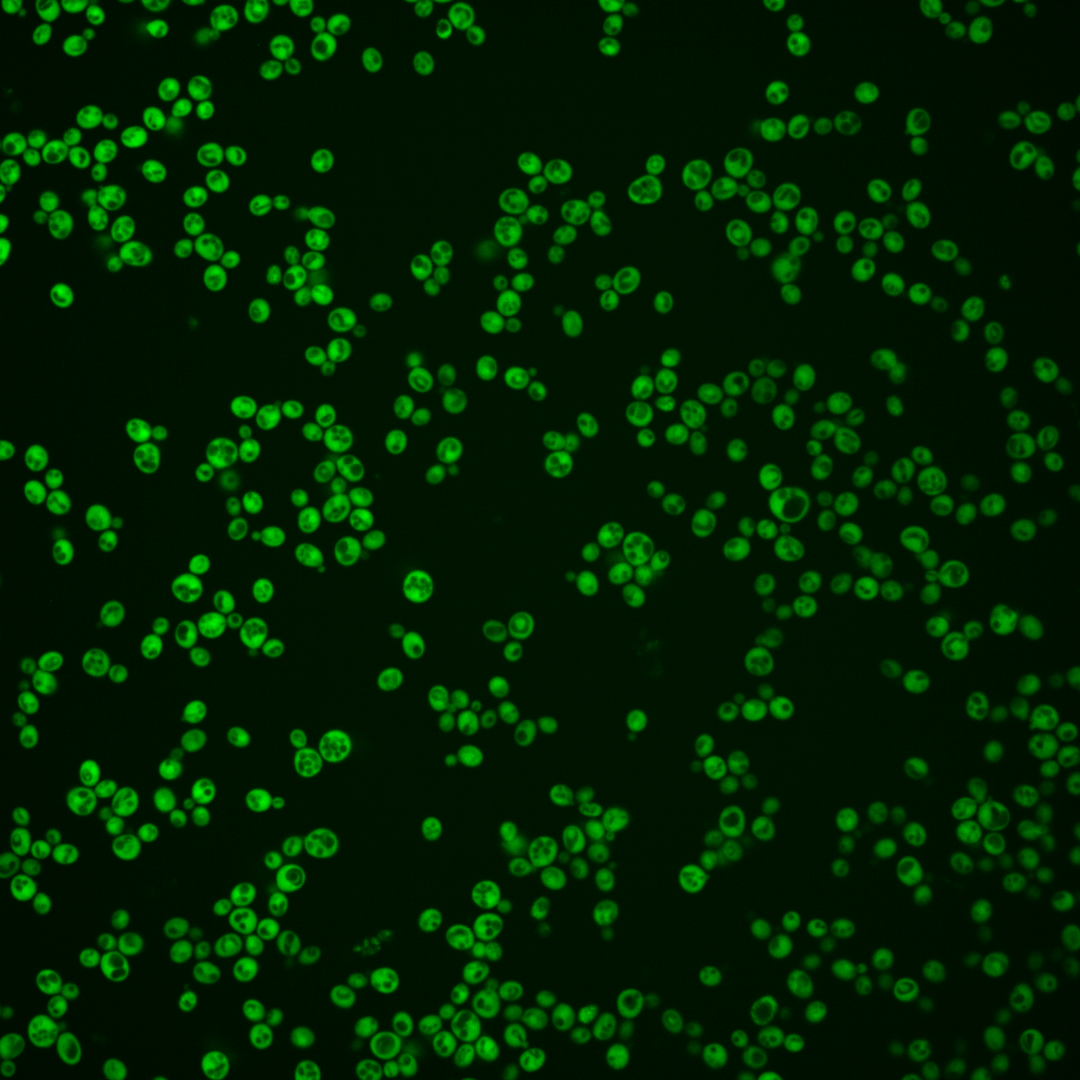
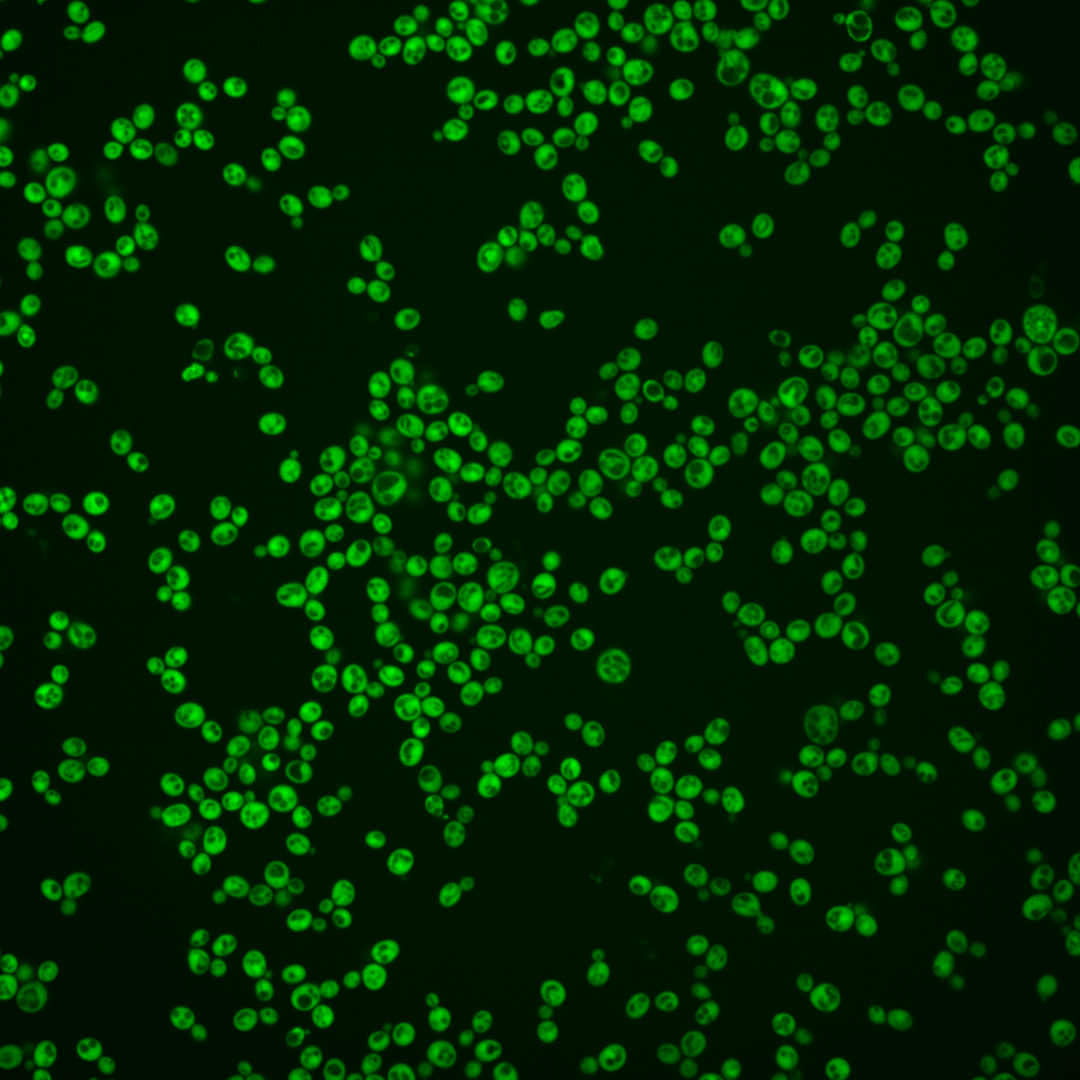
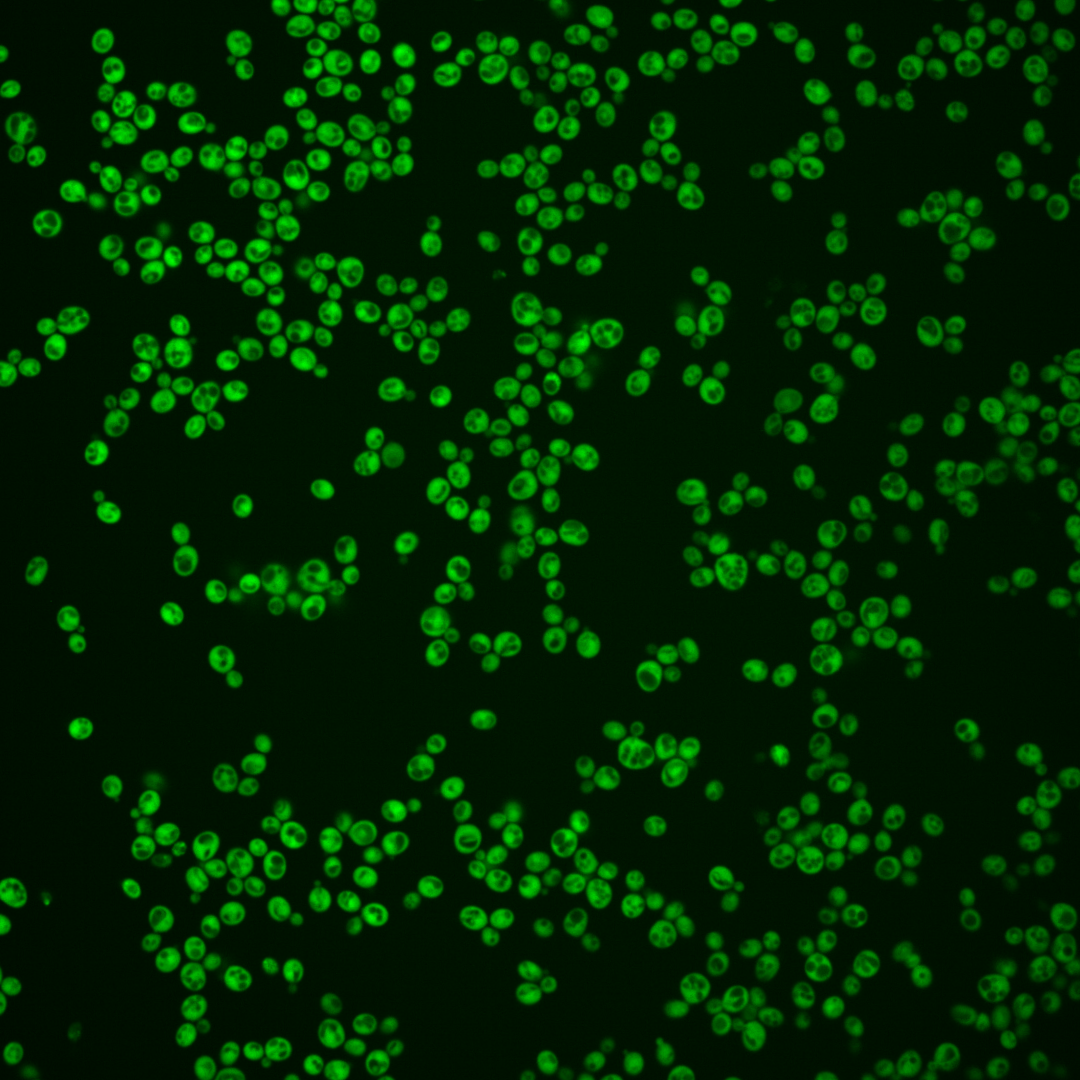
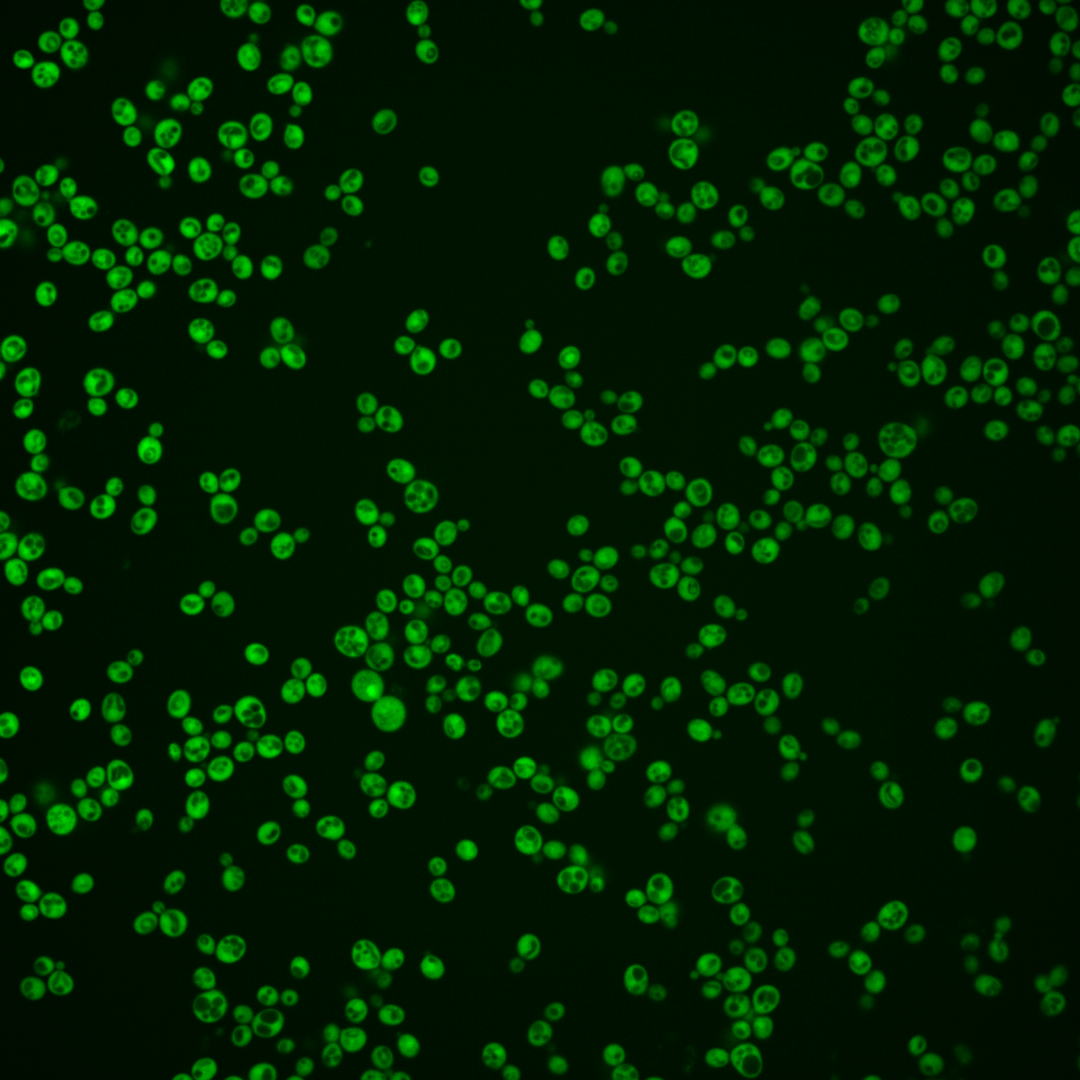

| Standard name | |
|---|---|
| Human Ortholog | |
| Description | Conserved phosphatase acting as a metabolite repair enzyme; shows specific dephosphorylating activity on two side-products of central carbohydrate metabolism, 2-phosphoglycolate and 4-phosphoerythronate; alkaline phosphatase specific for p-nitrophenyl phosphate; also has protein phosphatase activity; human ortholog PGP shows similar substrate specificity, deletion causes similar metabolite accumulation phenotypes, suggesting conserved role in eliminating glycolytic byproducts |
Micrographs




















































































Sub-cellular Localization
Yeast GFP Assignment
Protein Abundance
Localization Change
External localization resources
| ensLOC | DeepLoc | |||||||||||||||||||||||
|---|---|---|---|---|---|---|---|---|---|---|---|---|---|---|---|---|---|---|---|---|---|---|---|---|
| Localization | WT1 | WT2 | WT3 | RAP60 | RAP140 | RAP220 | RAP300 | RAP380 | RAP460 | RAP540 | RAP620 | RAP700 | HU80 | HU120 | HU160 | rpd3Δ_1 | rpd3Δ_2 | rpd3Δ_3 | WT1 | WT2 | WT3 | AF100 | AF140 | AF180 |
| Cortical Patches | 0 | 0 | 0 | 1 | 0 | 1 | 1 | 2 | 2 | 5 | 1 | 2 | 0 | 0 | 0 | 0 | 0 | 1 | 0 | 0 | 0 | 0 | 0 | 0 |
| Bud | 0 | 0 | 0 | 0 | 0 | 2 | 1 | 0 | 4 | 1 | 0 | 1 | 0 | 0 | 0 | 0 | 0 | 0 | 0 | 0 | 0 | 0 | 0 | 1 |
| Bud Neck | 0 | 0 | 0 | 0 | 0 | 0 | 0 | 0 | 0 | 0 | 0 | 1 | 0 | 0 | 0 | 0 | 0 | 0 | 0 | 0 | 0 | 0 | 0 | 0 |
| Bud Site | 0 | 0 | 0 | 0 | 0 | 0 | 0 | 0 | 0 | 0 | 0 | 0 | 0 | 0 | 0 | 0 | 0 | 0 | – | – | – | – | – | – |
| Cell Periphery | 1 | 2 | 1 | 7 | 8 | 12 | 4 | 8 | 15 | 17 | 3 | 16 | 3 | 2 | 5 | 2 | 9 | 5 | 0 | 0 | 0 | 0 | 0 | 0 |
| Cytoplasm | 245 | 168 | 138 | 286 | 373 | 343 | 392 | 322 | 229 | 294 | 186 | 297 | 338 | 496 | 517 | 69 | 181 | 140 | 238 | 159 | 145 | 124 | 396 | 335 |
| Endoplasmic Reticulum | 0 | 0 | 0 | 2 | 4 | 13 | 25 | 27 | 10 | 24 | 6 | 26 | 2 | 2 | 3 | 2 | 7 | 3 | 0 | 0 | 1 | 0 | 1 | 3 |
| Endosome | 0 | 0 | 0 | 0 | 0 | 0 | 0 | 0 | 0 | 0 | 0 | 0 | 0 | 0 | 0 | 0 | 0 | 0 | 0 | 0 | 0 | 0 | 0 | 0 |
| Golgi | 0 | 0 | 0 | 0 | 0 | 0 | 0 | 0 | 1 | 0 | 0 | 0 | 0 | 0 | 0 | 0 | 0 | 1 | 0 | 0 | 0 | 0 | 0 | 0 |
| Mitochondria | 1 | 0 | 0 | 0 | 0 | 0 | 4 | 3 | 12 | 5 | 15 | 5 | 0 | 0 | 0 | 1 | 0 | 1 | 0 | 0 | 1 | 0 | 0 | 0 |
| Nucleus | 0 | 0 | 1 | 2 | 2 | 3 | 7 | 3 | 5 | 10 | 4 | 4 | 1 | 0 | 0 | 0 | 1 | 1 | 0 | 2 | 1 | 3 | 0 | 0 |
| Nuclear Periphery | 0 | 0 | 0 | 0 | 0 | 0 | 0 | 0 | 0 | 0 | 0 | 0 | 0 | 0 | 0 | 0 | 0 | 0 | 0 | 0 | 0 | 0 | 0 | 0 |
| Nucleolus | 0 | 0 | 0 | 0 | 0 | 0 | 0 | 0 | 0 | 0 | 0 | 0 | 0 | 0 | 0 | 0 | 0 | 0 | 0 | 0 | 0 | 0 | 0 | 0 |
| Peroxisomes | 0 | 0 | 0 | 0 | 0 | 0 | 0 | 0 | 0 | 0 | 0 | 0 | 0 | 0 | 0 | 0 | 0 | 0 | 0 | 0 | 0 | 0 | 0 | 0 |
| SpindlePole | 0 | 0 | 0 | 0 | 0 | 0 | 0 | 0 | 0 | 0 | 0 | 1 | 0 | 0 | 0 | 0 | 0 | 0 | 0 | 0 | 0 | 0 | 0 | 0 |
| Vac/Vac Membrane | 0 | 0 | 0 | 1 | 5 | 11 | 15 | 21 | 7 | 21 | 19 | 42 | 1 | 0 | 6 | 3 | 6 | 0 | 0 | 3 | 1 | 0 | 0 | 1 |
| Unique Cell Count | 246 | 168 | 139 | 289 | 382 | 368 | 437 | 372 | 272 | 355 | 225 | 378 | 340 | 498 | 523 | 71 | 188 | 145 | 240 | 166 | 157 | 131 | 402 | 349 |
| Labelled Cell Count | 247 | 170 | 140 | 299 | 392 | 385 | 449 | 386 | 285 | 377 | 234 | 395 | 345 | 500 | 531 | 77 | 204 | 152 | 240 | 166 | 157 | 131 | 402 | 349 |
Yeast GFP Assignment
Protein Abundance
| Screen | WT1 | WT2 | WT3 | RAP60 | RAP140 | RAP220 | RAP300 | RAP380 | RAP460 | RAP540 | RAP620 | RAP700 | HU80 | HU120 | HU160 | rpd3Δ_1 | rpd3Δ_2 | rpd3Δ_3 | AF100 | AF140 | AF180 |
|---|---|---|---|---|---|---|---|---|---|---|---|---|---|---|---|---|---|---|---|---|---|
| Mean Cell GFP Intensity (1e-4) | 18.5 | 26.8 | 21.7 | 20.8 | 21.2 | 18.0 | 15.9 | 16.4 | 14.2 | 14.6 | 13.3 | 14.2 | 23.1 | 23.5 | 22.1 | 33.5 | 32.5 | 31.6 | 20.9 | 23.6 | 24.0 |
| Std Deviation (1e-4) | 3.5 | 4.7 | 4.4 | 3.8 | 3.7 | 3.3 | 3.2 | 3.3 | 3.0 | 2.8 | 2.9 | 3.0 | 4.6 | 4.1 | 4.2 | 8.0 | 7.5 | 9.6 | 4.8 | 4.0 | 4.8 |
| Intensity Change (Log2) | – | – | – | -0.06 | -0.03 | -0.27 | -0.45 | -0.4 | -0.61 | -0.57 | -0.71 | -0.61 | 0.1 | 0.12 | 0.03 | 0.63 | 0.58 | 0.54 | -0.05 | 0.12 | 0.15 |
Localization Change
| Localization | RAP60 | RAP140 | RAP220 | RAP300 | RAP380 | RAP460 | RAP540 | RAP620 | RAP700 | HU80 | HU120 | HU160 | rpd3Δ_1 | rpd3Δ_2 | rpd3Δ_3 |
|---|---|---|---|---|---|---|---|---|---|---|---|---|---|---|---|
| Cortical Patches | 0 | 0 | 0 | 0 | 0 | 0 | 0 | 0 | 0 | 0 | 0 | 0 | 0 | 0 | 0 |
| Bud | 0 | 0 | 0 | 0 | 0 | 0 | 0 | 0 | 0 | 0 | 0 | 0 | 0 | 0 | 0 |
| Bud Neck | 0 | 0 | 0 | 0 | 0 | 0 | 0 | 0 | 0 | 0 | 0 | 0 | 0 | 0 | 0 |
| Bud Site | 0 | 0 | 0 | 0 | 0 | 0 | 0 | 0 | 0 | 0 | 0 | 0 | 0 | 0 | 0 |
| Cell Periphery | 0 | 0 | 0 | 0 | 0 | 2.4 | 2.2 | 0 | 0 | 0 | 0 | 0 | 0 | 0 | 0 |
| Cytoplasm | -0.3 | -1.2 | -2.8 | -3.6 | -4.3 | -4.7 | -5.0 | -4.9 | -5.7 | 0.2 | 0.5 | -0.4 | -1.2 | -1.7 | -1.6 |
| Endoplasmic Reticulum | 0 | 0 | 0 | 2.9 | 3.3 | 0 | 3.1 | 0 | 3.2 | 0 | 0 | 0 | 0 | 0 | 0 |
| Endosome | 0 | 0 | 0 | 0 | 0 | 0 | 0 | 0 | 0 | 0 | 0 | 0 | 0 | 0 | 0 |
| Golgi | 0 | 0 | 0 | 0 | 0 | 0 | 0 | 0 | 0 | 0 | 0 | 0 | 0 | 0 | 0 |
| Mitochondria | 0 | 0 | 0 | 0 | 0 | 0 | 0 | 3.1 | 0 | 0 | 0 | 0 | 0 | 0 | 0 |
| Nucleus | 0 | 0 | 0 | 0 | 0 | 0 | 0 | 0 | 0 | 0 | 0 | 0 | 0 | 0 | 0 |
| Nuclear Periphery | 0 | 0 | 0 | 0 | 0 | 0 | 0 | 0 | 0 | 0 | 0 | 0 | 0 | 0 | 0 |
| Nucleolus | 0 | 0 | 0 | 0 | 0 | 0 | 0 | 0 | 0 | 0 | 0 | 0 | 0 | 0 | 0 |
| Peroxisomes | 0 | 0 | 0 | 0 | 0 | 0 | 0 | 0 | 0 | 0 | 0 | 0 | 0 | 0 | 0 |
| SpindlePole | 0 | 0 | 0 | 0 | 0 | 0 | 0 | 0 | 0 | 0 | 0 | 0 | 0 | 0 | 0 |
| Vacuole | 0 | 0 | 0 | 0 | 2.9 | 0 | 2.9 | 3.5 | 4.1 | 0 | 0 | 0 | 0 | 0 | 0 |
External localization resources
Images






























Protein Concentration and Protein Localization Data
| R1 | R2 | R3 | ||||||||||||||||
|---|---|---|---|---|---|---|---|---|---|---|---|---|---|---|---|---|---|---|
| G1 Pre-START | G1 Post-START | S/G2 | Metaphase | Anaphase | Telophase | G1 Pre-START | G1 Post-START | S/G2 | Metaphase | Anaphase | Telophase | G1 Pre-START | G1 Post-START | S/G2 | Metaphase | Anaphase | Telophase | |
| Concentration | 12.6238 | 14.9206 | 13.612 | 11.4812 | 11.7327 | 14.0985 | 13.7159 | 18.0983 | 15.8797 | 17.0315 | 12.9297 | 16.4828 | 14.0586 | 18.7526 | 15.4526 | 17.3463 | 9.8577 | 15.3939 |
| Actin | 0.0091 | 0.0004 | 0.0035 | 0.0044 | 0.0091 | 0.0003 | 0.0082 | 0.0015 | 0.01 | 0.0002 | 0.0091 | 0.0044 | 0.0132 | 0.0011 | 0.0127 | 0.012 | 0.029 | 0.0008 |
| Bud | 0.0005 | 0.0006 | 0.0003 | 0.0013 | 0.0003 | 0.0002 | 0.0005 | 0.0031 | 0.0009 | 0.0001 | 0.0016 | 0.0005 | 0.0007 | 0.0018 | 0.0012 | 0.0001 | 0.0003 | 0.0003 |
| Bud Neck | 0.0006 | 0.0002 | 0.0005 | 0.0005 | 0.0007 | 0.0009 | 0.0013 | 0.0002 | 0.0005 | 0.0004 | 0.0017 | 0.0011 | 0.001 | 0.0001 | 0.0006 | 0.0003 | 0.0007 | 0.0009 |
| Bud Periphery | 0.0013 | 0.0001 | 0.0002 | 0.0008 | 0.0002 | 0.0001 | 0.0004 | 0.0005 | 0.0005 | 0 | 0.0022 | 0.0002 | 0.0006 | 0.0003 | 0.0018 | 0.0001 | 0.0004 | 0.0009 |
| Bud Site | 0.0004 | 0.0012 | 0.0006 | 0.0007 | 0.0004 | 0 | 0.0014 | 0.0007 | 0.0007 | 0 | 0.0022 | 0.0002 | 0.0036 | 0.0014 | 0.0064 | 0.0002 | 0.0016 | 0.0001 |
| Cell Periphery | 0.0001 | 0 | 0.0002 | 0.0001 | 0.0001 | 0 | 0.0002 | 0 | 0.0001 | 0 | 0.0003 | 0.0001 | 0.0001 | 0.0001 | 0.0001 | 0 | 0.0001 | 0.0001 |
| Cytoplasm | 0.8959 | 0.9774 | 0.9394 | 0.897 | 0.8292 | 0.9583 | 0.8701 | 0.9806 | 0.9316 | 0.9802 | 0.749 | 0.9373 | 0.896 | 0.9866 | 0.908 | 0.9375 | 0.7598 | 0.9554 |
| Cytoplasmic Foci | 0.0089 | 0.0016 | 0.0068 | 0.0099 | 0.0145 | 0.0016 | 0.0186 | 0.0011 | 0.0059 | 0.0005 | 0.0081 | 0.0037 | 0.0141 | 0.0014 | 0.0133 | 0.0045 | 0.046 | 0.0012 |
| Eisosomes | 0.0001 | 0 | 0.0001 | 0 | 0.0002 | 0 | 0.0001 | 0 | 0.0001 | 0 | 0.0002 | 0.0001 | 0.0001 | 0 | 0.0002 | 0.0001 | 0.0004 | 0 |
| Endoplasmic Reticulum | 0.0061 | 0.0022 | 0.0039 | 0.0079 | 0.0102 | 0.002 | 0.0064 | 0.0005 | 0.0047 | 0.0007 | 0.0108 | 0.0024 | 0.0058 | 0.0003 | 0.0022 | 0.0006 | 0.0056 | 0.0012 |
| Endosome | 0.0154 | 0.0005 | 0.0073 | 0.012 | 0.0349 | 0.0013 | 0.0181 | 0.0002 | 0.0043 | 0.0002 | 0.0383 | 0.0059 | 0.0142 | 0.0002 | 0.0062 | 0.005 | 0.0261 | 0.0029 |
| Golgi | 0.0022 | 0 | 0.0038 | 0.0018 | 0.0114 | 0.0001 | 0.0029 | 0 | 0.0013 | 0 | 0.0076 | 0.0017 | 0.0034 | 0 | 0.0023 | 0.0048 | 0.0141 | 0.0009 |
| Lipid Particles | 0.0015 | 0 | 0.0015 | 0.001 | 0.0258 | 0 | 0.007 | 0 | 0.0031 | 0 | 0.0383 | 0.0026 | 0.0054 | 0 | 0.0038 | 0.0169 | 0.0609 | 0.0008 |
| Mitochondria | 0.0049 | 0.0001 | 0.0011 | 0.0053 | 0.0056 | 0.0019 | 0.0039 | 0.0003 | 0.0024 | 0.0001 | 0.0171 | 0.0019 | 0.0071 | 0.0001 | 0.0133 | 0.0018 | 0.0133 | 0.0186 |
| None | 0.0046 | 0.0012 | 0.0011 | 0.003 | 0.0031 | 0.0008 | 0.006 | 0.0008 | 0.0027 | 0.0004 | 0.0046 | 0.0022 | 0.0025 | 0.0006 | 0.0012 | 0.0011 | 0.0043 | 0.0005 |
| Nuclear Periphery | 0.0088 | 0.0029 | 0.0042 | 0.013 | 0.0176 | 0.0043 | 0.0077 | 0.0015 | 0.0081 | 0.0022 | 0.0315 | 0.0056 | 0.0075 | 0.0008 | 0.0064 | 0.0015 | 0.0054 | 0.0022 |
| Nucleolus | 0.0006 | 0 | 0.0001 | 0.0001 | 0.0003 | 0.0001 | 0.0005 | 0 | 0.0001 | 0 | 0.0032 | 0.001 | 0.0002 | 0 | 0.0005 | 0 | 0.0003 | 0.0001 |
| Nucleus | 0.0253 | 0.0105 | 0.0211 | 0.032 | 0.0177 | 0.0267 | 0.0263 | 0.0083 | 0.0181 | 0.0144 | 0.0334 | 0.0237 | 0.013 | 0.0046 | 0.0146 | 0.0061 | 0.0076 | 0.0083 |
| Peroxisomes | 0.0012 | 0 | 0.0012 | 0.0009 | 0.0086 | 0 | 0.0051 | 0.0001 | 0.0018 | 0 | 0.017 | 0.0004 | 0.0046 | 0 | 0.0023 | 0.0058 | 0.0153 | 0.0001 |
| Punctate Nuclear | 0.0071 | 0.0005 | 0.0006 | 0.0037 | 0.0053 | 0.0004 | 0.01 | 0.0003 | 0.0016 | 0.0002 | 0.0126 | 0.0025 | 0.0043 | 0.0002 | 0.0015 | 0.0006 | 0.0061 | 0.0004 |
| Vacuole | 0.0034 | 0.0004 | 0.0019 | 0.0031 | 0.0027 | 0.0008 | 0.0039 | 0.0002 | 0.0011 | 0.0003 | 0.0072 | 0.0016 | 0.0017 | 0.0002 | 0.0007 | 0.0004 | 0.0015 | 0.0016 |
| Vacuole Periphery | 0.002 | 0.0001 | 0.0004 | 0.0014 | 0.002 | 0.0003 | 0.0013 | 0 | 0.0005 | 0.0001 | 0.004 | 0.001 | 0.0008 | 0 | 0.0005 | 0.0003 | 0.0013 | 0.0027 |
Sequencing Data
| R1 | R2 | |||||||||
|---|---|---|---|---|---|---|---|---|---|---|
| G1 Post-START | S/G2 | Metaphase | Anaphase | Telophase | G1 Post-START | S/G2 | Metaphase | Anaphase | Telophase | |
| Gene Expression | 59.3418 | 56.7245 | 48.3279 | 58.7503 | 68.5597 | 44.6285 | 52.3091 | 56.2731 | 60.432 | 61.5363 |
| Translational Efficiency | 2.2263 | 1.9328 | 2.2231 | 1.9289 | 1.466 | 2.9166 | 2.4905 | 1.9176 | 1.9843 | 2.0775 |
Hit Data
| Dataset | Hit |
|---|---|
| Protein Concentration | ✘ |
| Protein Localization | ✔ |
| Gene Expression | ✘ |
| Translational Efficiency | ✘ |
Endocytosis
| Temp | Actin Patch (Sac6-tdTomato) | Cortical Patch (Sla1-GFP) | Late Endosome (Snf7-GFP) | Vacuole (Vph1-GFP) |
|---|---|---|---|---|
| 37℃ | ||||
| RT |
Cell Cycle Omics
CYCLoPs (Pho13-GFP)
| Gene / Allele | Actin Patch (Sac6-tdTomato) | Cortical Patch (Sla1-GFP) | Late Endosome (Snf7-GFP) | Vacuole (Sac6-tdTomato) |
|---|
| Gene | Images |
|---|
| Gene | Images |
|---|
Images are not yet available
Images are not yet available